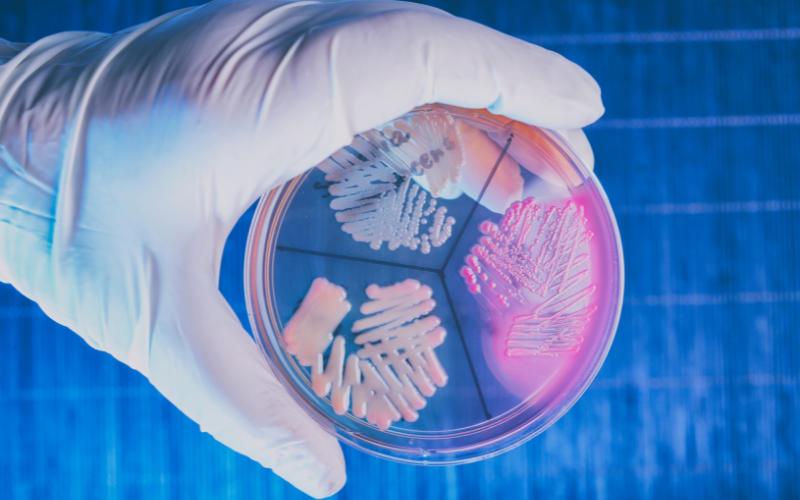
Bakterie

Wiele klimatyzatorów poza chłodzeniem może oczyszczać powietrze z alergenów i szkodliwych zanieczyszczeń. Klimatyzatory z oczyszczaczem to urządzenia, które pomogą Ci się uporać z zanieczyszczeniami wpadającymi przez okna, takimi jak pyłki roślin, czy cząstki smogu.
Warto zaopatrzyć się w te urządzenia latem i wiosną, czyli w sezonie alergicznym, kiedy temperatura jest najwyższa. W tym artykule sprawdzimy, jakie technologie skutecznie oczyszczają oraz czy filtry w klimatyzatorach przenośnych i ściennych działają skutecznie.
Spis treści:
Dlaczego klimatyzatory z funkcją oczyszczaczania powietrza zyskują na popularności?
Z roku na rok zwiększa się nasza świadomość w temacie zanieczyszczeń powietrza.
W 2020 roku Polski Instytut Ekonomiczny sporządził raport, zgodnie z którym 2/3 ankietowanych Polaków bierze pod uwagę wpływ zanieczyszczeń powietrza na zdrowie swoje i swoich bliskich, a 27% ankietowanych określiło stan powietrza we własnym domu jako zły.
Co zanieczyszcza domowe powietrze?
- stosowanie chemicznych środków czystości,
- stosowanie farb, lakierów do podłóg, itp.,
- palenie tytoniu w pomieszczeniach,
- nagromadzenie roztoczy kurzu i pleśni,
- zanieczyszczenia wpadające przez otwarte okna, w tym pyłki roślin i cząsteczki smogowe.
Klimatyzatory z oczyszczaczem powietrza — popularne modele
Wśród klimatyzatorów domowych wykorzystujących technologię oczyszczania powietrza znajdziemy modele typu split, czyli klimatyzację przeznaczoną do montażu na stałe oraz klimatyzator przenośny.
Montaż klimatyzatora przenośnego z oczyszczaczem powietrza, w odróżnieniu od klimatyzacji split, nie wymaga uzyskania żadnych zezwoleń i można wykonać go samodzielnie.
Jeśli chcesz poznać inne tryby pracy klimatyzacji, koniecznie przeczytaj nasz artykuł:
Parametry klimatyzatorów przenośnych
Klimatyzator przenośny
Czy wiesz jaki klimatyzator przenośny z funkcją oczyszczania wybrać? Sprawdź nasze propozycje:
Fersk Vind 2 – dla alergików i astmatyków

Sprawdź na homespot.pl
Przeczytaj recenzję
Cena | 2 299 zł |
Oczyszczanie: | filtr HEPA Allergy Protect
|
Do powierzchni | 43 m² |
Klasa energetyczna: | A / A+ |
Moc chłodnicza | 3,5 kW |
Przepływ powietrza: | 380 m³ / h |
Tryby pracy | chłodzenie ogrzewanie osuszanie oczyszczanie cyrkulacja |
Klimatyzator z oczysczzaczem Fersk Vind 2 oczyszcza powietrze z wysoką efektywnością dzięki filtrowi HEPA Allergy Protect o klasie skuteczności H13 (99,95% skuteczności). W naszym teście oczyścił on pomieszczenie o wielkości 14 m² w 12 minut i 46 sekund. Jest to wynik porównywalny z domowymi oczyszczaczami powietrza.
Welltec ACN18 – wydajny sprzęt z filtrem HEPA H13

Sprawdź na Ceneo
Przeczytaj recenzję
Cena: | 3 450 zł |
Oczyszczanie: | filtr HEPA H13 |
Do powierzchni: | 52 m² |
Klasa energetyczna: | A |
Moc grzewcza | 4,7 kW |
Moc chłodnicza: | 5,2 kW |
Przepływ powietrza: | 680 m³/h |
Tryby pracy: | chłodzenie osuszanie oczyszczanie cyrkulacja |
Whirlpool PACW29COL – klimatyzator z bardzo małym filtrem HEPA

Sprawdź na Ceneo
Przeczytaj recenzję
Cena: | 1 329 zł |
Oczyszczanie: | Filtr HEPA |
Do powierzchni: | 9 - 18 m² |
Klasa energetyczna: | A |
Moc chłodnicza: | 2,8 kW |
Przepływ powietrza: | 380 m³/h |
Tryby pracy: | chłodzenie osuszanie cyrkulacja |
Klimatyzator z oczyszczaczem Whirlpool PACW29COL zdobył dużą popularność. Niestety ten model nie sprawdza się podczas oczyszczania.
Wszystko przez mały filtr HEPA, który nie oczyszcza powietrza, ponieważ nie jest w stanie zasłonić całego wlotu powietrza.
Filtr HEPA w klimatyzatorze Whirlpool PACW29COL jest o wiele mniejszy od tradycyjnego filtra (patrz na zdjęcie). Do tego jest on giętki i podatny na uszkodzenia.
W tym wypadku funkcja oczyszczania jest jedynie wartością marketingową i wprowadzeniem użytkownika w błąd.

Szukasz dobrego klimatyzatora przenośnego z filtrem HEPA? Sprawdź recenzję modelu Fersk Lite, który wydajnie oczyszcza powietrze.
https://www.youtube.com/watch?v=rHTw7oc733M
Aby poznać więcej modeli klimatyzatorów, odwiedź nasz ranking. w którym Fersk Vind 2 z funkcją oczyszczania zajmuje 1. miejsce.
Zobacz ranking klimatyzatorów przenośnych
Klimatyzatory split
Czy wiesz jaki klimatyzator z oczyszczaczem powietrza wybrać w wersji split? Sprawdź nasze propozycje topowych modeli:
Gree Lomo Eco — idealny dla alergików
Cena | 2 250 zł |
Oczyszczanie: | filtry powietrza
|
Do powierzchni | 40 m² |
Klasa energetyczna: | A ++ / A+ |
Moc chłodnicza | 3,2 kW |
Przepływ powietrza: | 560 m³ / h |
Tryby pracy | chłodzenie ogrzewanie osuszanie oczyszczanie jonizacja |
Haier Jade Plus 3,5 kW — ekonomiczny model z filtrem IFD
Cena | 6 053 zł |
Oczyszczanie: | filtr IFD
|
Do powierzchni | 25 - 35 m² |
Klasa energetyczna: | A +++ / A+++ |
Moc chłodnicza | 3,2 kW |
Przepływ powietrza: | 600 m³ / h |
Tryby pracy | chłodzenie ogrzewanie osuszanie oczyszczanie |
Rotenso Versu Mirror — dla alergików i astmatyków z filtrem HD iAIR
Cena | 3 849 zł |
Oczyszczanie: | filtr HD iAIR
|
Do powierzchni | 43 m² |
Klasa energetyczna: | A +++ / A++ |
Moc chłodnicza | 3,5 kW |
Przepływ powietrza: | 530 m³ / h |
Tryby pracy | chłodzenie ogrzewanie oczyszczanie jonizacja |
LG Deluxe DC09RQ 2,5 kW – klimatyzator z efektywnym oczyszczaniem i jonizacją
Cena | 3 694 zł |
Oczyszczanie: | filtr alergiczny
|
Do powierzchni | 30 m² |
Klasa energetyczna: | A ++ / A++ |
Moc chłodnicza | 2,5 kW |
Przepływ powietrza: | 750 m³ / h |
Tryby pracy | chłodzenie ogrzewanie oczyszczanie jonizacja |
Whirlpool SPIW309A2WF – oszczędność energii i szybkie chłodzenie
Cena | 3 999 zł |
Oczyszczanie: | filtr HEPA
|
Do powierzchni | 24 m² |
Klasa energetyczna: | A ++ / A+ |
Moc chłodnicza | 2,6 kW |
Przepływ powietrza: | 700 m³ / h |
Tryby pracy | chłodzenie ogrzewanie osuszanie oczyszczanie jonizacja |
Kiedy stosować klimatyzatory przenośne?
Wiosna i lato to czas, kiedy alergeny wziewne szczególnie uprzykrzają życie alergikom i astmatykom, a przy okazji rozpoczyna się okres upałów, dlatego klimatyzator z funkcją oczyszczania powietrza może okazać się szczególnie przydatnym urządzeniem.
Klimatyzator z oczyszczaczem powietrza – jakie posiada filtry?
Wszystkie z wymienionych filtrów mają zdolność do mniej lub bardziej skutecznego wyłapywania różnego rodzaju zanieczyszczeń, w tym alergenów: sierści, kurzu, pyłków, pyłów smogowych, etc.
Klimatyzator z funkcją oczyszczania powietrza wykorzystujący filtry będzie więc dobrym wyborem dla alergików i astmatyków.

Filtr wstępny

Nazwany tak dlatego, że znajduje się tuż pod pokrywą zewnętrzną klimatyzatora. Dzięki swojej siateczkowej budowie zatrzymuje większe alergeny, takie jak kurz, pyłki, sierść.
Filtr wymaga czyszczenia min. raz w tygodniu, by osiadłe na nim zanieczyszczenia nie zmniejszały przepływu powietrza i tym samym wydajności filtracji.
Filtr typu HEPA/EPA

High Efficiency Particulate Air, czyli wysoce skuteczny cząsteczkowy filtr powietrza, wyróżnia się dużą precyzją w pochłanianiu zanieczyszczeń i alergenów, takich jak:
- smogowe pyły zawieszone PM10, PM2,5 i PM1;
- roztocza kurzu domowego;
- pyłki roślin;
- bakterie i wirusy.
Jego skuteczność wynika ze specyficznej budowy – cienkie arkusze z mikroskopijnymi włóknami tworzącymi harmonijkę są w stanie zatrzymać do 99,95% cząsteczek o wielkości 0,3 mikrona.
Przykładem jest marka Rotenso, której filtr antybakteryjny HEPA iAIR zatrzymuje 99,97% zanieczyszczeń. Filtr ten dodatkowo wykorzystuje enzymy, które „żywią” się komórkami grzybów, pierwotniaków, bakterii i wirusów.
Dzięki swojej skuteczności klimatyzator oczyszczacz posiadający filtr HEPA, jest polecany dla alergików i astmatyków.
Warto zwracać uwagę na klasyfikację filtrów, która określa całkowitą skuteczność filtracji wyrażoną w procentach:
- EPA E10 – 85%
- EPA E11 – 95%
- EPA E12 – 99,5%
- HEPA H13 – 99,95%
- HEPA H14 – 99,995%
Filtry HEPA/EPA odkurzamy min. raz w miesiącu, by zwiększyć żywotność filtra.
Częstotliwość jego wymiany zależy od poziomu zanieczyszczenia powietrza w naszym domu.
Filtr elektrostatyczny

Filtr tego typu posiada powierzchnię naładowaną ujemnie, dzięki czemu z łatwością przyciąga zanieczyszczenia o ładunku dodatnim, oczyszczając powietrze z pyłków i kurzu.
W przeciwieństwie do technologii jonizacji w klimatyzatorze z funkcją oczyszczania, filtr elektrostatyczny nie wysyła jonów do pomieszczenia, a działa tylko wewnątrz urządzenia, oczyszczając zassane powietrze.
Zgromadzone na elektrodzie filtra zanieczyszczenia trzeba regularnie wypłukiwać, by zachować skuteczność filtracji powietrza.
Aktywny filtr węglowy
Ten przypominający plaster miodu filtr ma zdolność do pochłaniania nie tylko alergenów, ale i toksycznych gazów i substancji, takich jak np.:
- benzen,
- formaldehyd,
- amoniak.
Filtr węglowy neutralizuje również nieprzyjemne zapachy. Podobnie, jak filtr HEPA, wymaga odkurzania raz na 2-4 tygodnie.
Filtr katechinowy

Katechiny, którymi powleczony jest ten rodzaj filtra, to związki polifenolowe występujące naturalnie np. w zielonej herbacie.
Filtr katechinowy ma zdolność do neutralizacji wirusów i bakterii oraz wychwytywania roztocza kurzu domowego. Dodatkowo ma on właściwości usuwające przykre zapachy.
Technologie w klimatyzatorach z funkcją oczyszczania powietrza
W klimatyzatorach z funkcją oczyszczania znajdziesz wiele przydatnych technologii. Są one ważne nie tylko dla alergików, ale także osób dbających o jakość powietrza. W klimatyzacji przenośnej i ściennej znajdziesz takie rozwiązania jak jonizacja, lampa UV oraz liczne filtry.
Jonizacja

Technologia jonizacji jest różnie nazywana przez producentów klimatyzatorów z funkcją oczyszczania.
LG ma jonizator plazmowy Plasmaster Plus, Rotenso ma iAIR, a Sharp – generator jonów Plasmacluster™. Wszystkie jednak opierają się na tej samej zasadzie działania.
Jonizator powietrza wytwarza jony ujemne, sterylizując zarówno to powietrze, które przechodzi przez urządzenie, jak i to, które znajduje się w pomieszczeniu.
Jony mają zdolność otaczania szkodliwych cząsteczek i przyciągania ich do filtra. Te cząsteczki to przede wszystkim:
- bakterie i wirusy,
- pyłki roślin,
- unoszący się kurz domowy zawierający roztocze,
- dym papierosowy,
- cząsteczki smogowe.
W wyniku następującej reakcji chemicznej, te szkodliwe substancje są przekształcane w cząsteczki H2O, a oddawane przez klimatyzator powietrze bogate w tlen łatwiej przedostaje się przez błony śluzowe do płuc.
Klimatyzatory ścienne lub przenośne z funkcją jonizacji są polecane dla dzieci, osób starszych oraz tych zmagających się z alergiami wziewnymi. Oczyszczone jonizatorem powietrze usprawnia pracę płuc i zmniejsza ryzyko infekcji górnych dróg oddechowych, jak również łagodzi objawy alergii.
Klimatyzator z funkcją oczyszczania wykorzystujący jonizację nie stwarza zagrożenia dla zdrowia, jeśli jest odpowiednio i regularnie czyszczony, ze szczególnym uwzględnieniem odgrzybiania przewodów klimatyzacyjnych.
Lampa UV-C

W popularnych serwisach aukcyjnych można dokupić lampy UV w formie modułu do klimatyzatora. Sprzedawcy opisują je jako rozwiązanie pozwalające na bezpieczną pracę klimatyzatorów, dzięki silnym właściwościom biobójczym lamp, które są w stanie zniszczyć bakterie, wirusy, pleśń, grzyby i inne drobnoustroje.
Według niektórych, lampy UV-C mogą minimalizować ryzyko zakażeń wtórnych, co wydawałoby się szczególnie istotne w przypadku obecnej pandemii.
Czy lampa UV jest skuteczna?
Naszym zdaniem moduł UV nie jest w stanie efektywnie neutralizować zanieczyszczeń w pomieszczeniu ze względu na niewielkie rozmiary. Rozwiązanie to może być skuteczne bardziej w odniesieniu do drobnoustrojów, które przepływają przez jednostkę, co może przyczynić się do dłuższej żywotności filtrów.
Podsumowanie
Klimatyzator pokojowy z funkcją oczyszczania powietrza to bardzo dobre rozwiązanie dla osób, które zmagają się z alergiami, cierpią na astmę lub chcą po prostu zadbać o stan powietrza w domu.
Taki klimatyzator łączący w sobie różne funkcje, daje możliwość używania go na różne sposoby – jeśli w danej chwili nie ma potrzeby chłodzenia pomieszczeń, może pracować wyłącznie jako oczyszczacz powietrza, co będzie się wiązało z mniejszym zużyciem energii i stworzy korzystny dla zdrowia mikroklimat.
Najbardziej skuteczne są klimatyzatory wykorzystujące technologię jonizacji oraz zestawy filtrów, co pozwala na skuteczne zmniejszenie lub całkowitą likwidację unoszących się w powietrzu alergenów i szkodliwych substancji.
Technologia UV-C nie jest uznawana za w pełni skuteczną, ale może być stosowana jako uzupełnienie pozostałych funkcji.
Wśród dostępnych modeli klimatyzatorów z funkcją oczyszczania powietrza znajdziemy klimatyzatory typu split do montażu naściennego oraz klimatyzator przenośny.
FAQ
Czy klimatyzator z oczyszczaczem ma sens?
Tak, warto przemyśleć zakup klimatyzatora oczyszczacza jako urządzenia 2 w 1. Sprzęt jest w stanie efektywnie usuwać zabrudzenia dzięki filtrom i technologiom automatycznego czyszczenia podzespołów.
Czy każdy klimatyzator ma funkcję oczyszczania powietrza?
Niestety nie. Funkcja oczyszczania powietrza jest związana z wyposażeniem klimatyzatora: musi mieć on filtr HEPA. Tego rodzaju filtr zatrzymuje zanieczyszczenia stałe, w tym smog, wirusy, bakterie, alergeny, zarodniki pleśni. Technologią wspierającą proces filtracji jest jonizacja powietrza, która zdecydowanie częściej występuje w klimatyzacji naściennej typu split.
Co lepsze filtr HEPA czy filtr węglowy w klimatyzacji?
Trudno odpowiedzieć na to pytanie. Każdy z tych filtrów usuwa inne rodzaje zanieczyszczeń, dlatego np. w oczyszczaczach powietrza występuje zarówno filtr węglowy, usuwający brzydkie zapachy i szkodliwe gazy, jak i filtr HEPA. W klimatyzacji częściej spotyka się filtr HEPA, który ma dłuższą żywotność i usuwa zanieczyszczenia stałe, czyli unoszące się w powietrzu alergeny, składniki smogu, zarodniki pleśni.
Czy filtr siatkowy w klimatyzatorze oczyszcza powietrze?
Tego rodzaju filtr zatrzymuje jedynie duże cząsteczki kurzu i niekiedy unoszące się w powietrzu włosy i sierść. Ma to na celu zabezpieczenie wnętrza urządzenia przed zabrudzeniem, który mogłoby skutkować zmniejszeniem wydajności. Filtr siatkowy, nazywany też wstępnym, nie spełnia roli oczyszczającej powietrze.
Na czym polega oczyszczanie w klimatyzatorze?
Klimatyzator poza filtrem wstępnym posiadają także filtry HEPA lub filtr węglowe. Są one w stanie usunąć większość zanieczyszczeń i zadbać o jakość powietrza w pomieszczeniu.
Jak działa klimatyzator z oczyszczaniem powietrza?
Klimatyzator z oczyszczaczem powietrze jest zdolny do filtrowania cząstek stałych i usuwania zanieczyszczeń, takich jak PM 10, PM 2,5. Warto dodać, że wiele klimatyzatorów posiada funkcję jonizacji, która neutralizuje obecne w powietrzu patogeny.
Źródła:
- Raport PIE – „Polacy i ochrona powietrza. Normy społeczne jako źródło zmiany?”
- https://twojegree.pl/aktywna-ochrona-jonizator-plazmowy-w-klimatyzacji/
- https://www.wentylacyjny.pl/2347-2-2-nowy-trend!-klimatyzator-i-oczyszczacz-powietrza-w-jednym.html
- https://erco-lodz.pl/klimatyzator-z-funkcja-oczyszczania-powietrza-synonim-komfortu-i-zdrowia/
- https://www.sharpdirect.pl/artykuly/klimatyzator-sharp-plasmacluster-cv-p10pr-ciesz-sie-orzezwiajacym-czystym-powietrzem-przez-caly-rok/index.html
- https://wybierzoczyszczacz.pl/poradniki/filtry-do-oczyszczaczy-powietrza/








